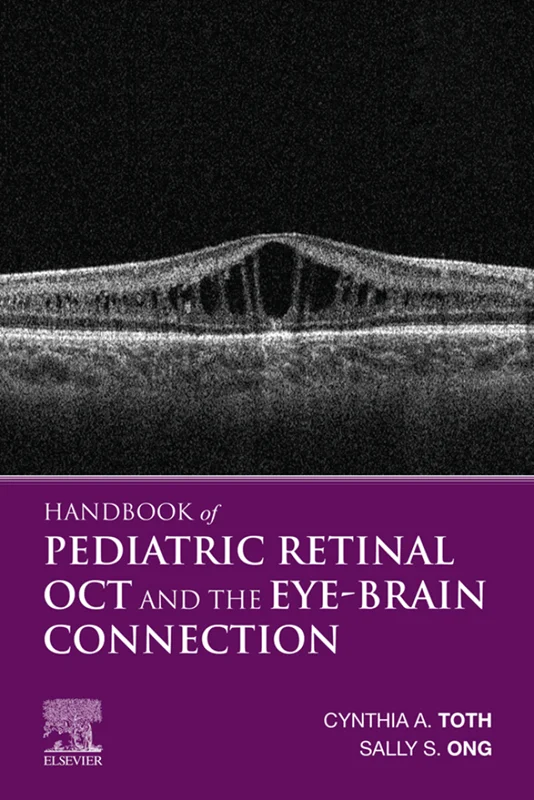
Handbook of Pediatric Retinal OCT and the Eye-Brain Connection

Handbook of Pediatric Retinal OCT and the Eye-Brain Connection
Cynthia A. Toth, Sharon F Freedman, Mays El-Dairi, Lejla Vajzovic, 9780323609845, 978-0323609845, 978-0-323-60984-5, B07X2XTN73, 0323609848, 0323609864, 9780323609869, 978-0323609869
English | 2020 | PDF | 148 MB | 351 Pages
Optical Coherence Tomography (OCT) plays a vital role in pediatric retina diagnosis, often revealing unrecognized retinal disorders and connections to brain injury, disease, and delayed neurodevelopment. Handbook of Pediatric Retinal OCT and the Eye-Brain Connection provides authoritative, up-to-date guidance in this promising area, showing how to optimize imaging in young children and infants, how to accurately interpret these images, and how to identify links between these images and brain and developmental disorders.
- Illustrates optimal methods of OCT imaging of children and infants, how to avoid pitfalls, and how to recognize and avoid artifacts
- Explains how the OCT image may relate to brain disease and delayed neurodevelopment
- Features more than 200 high-quality images and scans that depict the full range of disease in infants and young children
- Provides guidance in identifying retinal layers and important abnormalities.
- Covers the structural features of the retina and optic nerve head in developmental, acquired, or inherited conditions that affect the eye and visual pathways
- Offers practical ways to set up imaging programs in the clinic, operating room, or neonatal nursery